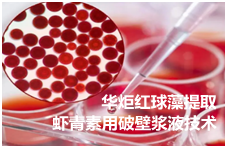

红球藻提取虾青素用破壁浆液技术配方及方法
雨生红球藻是一种生活在淡水中的单细胞绿藻,在特定条件下能积累大量的类胡萝卜素(可达干重的2% -5%),其中80%以上为虾青素及其酯类D。雨生红球藻的生活周期主要分为营养细胞和厚壁孢子,一般认为环境有利时,形成营养孢子;环境不利时,形成厚壁孢子并大量累积虾青素。虾青素可作为脂溶性的色素,具有艳丽的红色和强的抗氧化性能;在食品工业中,不仅能有效起到保鲜、保色、保味、保质等作用,而且能为多类食品着色,增加食品的色泽美感;另外动物实验表明虾青素有抑制肿瘤发生、增强免疫功能等多方面的生理作用,因此虾青素在功能食品和医药等方面应用广泛。利用有机溶剂可以直接从雨生红球藻细胞中提取虾青素,但是由于雨生红球藻的厚壁孢子具有坚韧的细胞壁,若直接利用将导致其生物有效利用率降低,而厚壁孢子结构又阻碍了有机溶剂进入细胞内提取虾青素,因而虾青素提取率较低。故在虾青素提取前必须先进行孢子态细胞的破壁处理,以破坏雨生红球藻的细胞结构,特别是其细胞壁的结构,而雨生红球藻的破壁方法对于虾青素的提取率和质量至关重要。
华炬新产品研究所技术咨询委员会科研人员现推荐一项红球藻提取虾青素用破壁浆液技术配方及方法,该技术冰浴条件下,破壁浆液可以更快的渗透到雨生红球藻细胞的表层;在匀浆过程中,利用螺旋桨施加的搅拌离心力、挤压力、剪切力对海藻细胞进行破碎,并且物料之间的摩擦力加速细胞表面的冰醋酸对细胞壁结构中糖蛋白的破坏;同时,由于冰浴的破壁浆液的介入避免了匀浆过程中温度的升高,最大程度的保护了虾青素的理化活性,所得的虾青素提取物为暗红色粘稠物质,细胞的破壁率高达97.7%,虾青素提取物的提取率达到37%,虾青素的提取率达到35.05%,产物中虾青素纯度极高达到95.25%,现将该红球藻提取虾青素用破壁浆液技术配方及方法及实例介绍如下供研究参考:(341511 634435)
